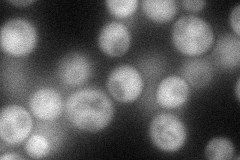
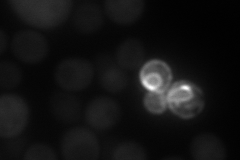
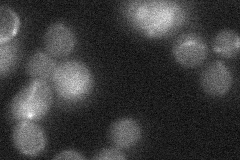
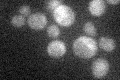

View description
Guanine deaminase, a catabolic enzyme of the guanine salvage pathway producing xanthine and ammonia from guanine; activity is low in exponentially-growing cultures but expression is increased in post-diauxic and stationary-phase cultures
Localization:
Intensity:
Fold change:
Significance:
-
C’ GFP library in SD

below threshold18.23 -
N' NOP1pr-GFP in SD
cytosol60.3676 -
N' TEF2pr-mCherry in SD
cytosol64.5296 -
N' NATIVEpr-GFP in SD
below threshold16.1168 -
N' TEF2pr-VC and Cyto-VN in SD

cytosol37.9458 -
C’ GFP library in SD+DTT

cytosol22.231.21No -
C’ GFP library in SD+H2O2

cytosol16.430.9No -
C’ GFP library in Starvation Media
cytosol23.331.27No -
C’ GFP library on the background of Pup2-DaMP

below threshold -
C’ GFP library on the background of CCT mutant

below threshold21.55471.1816No
